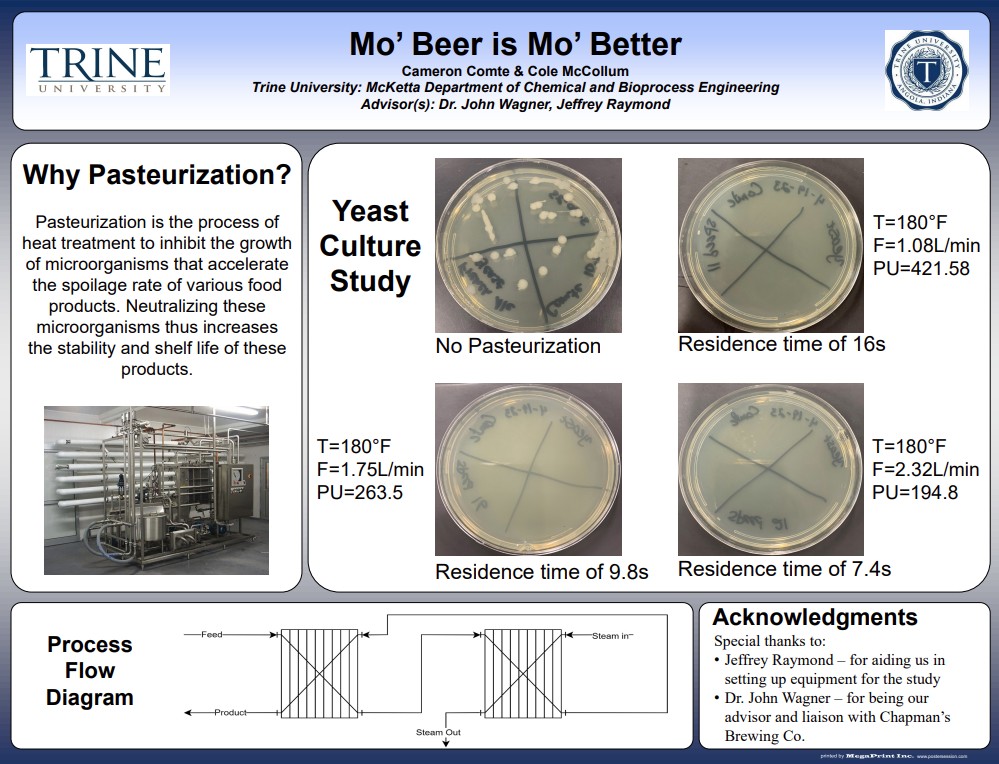
mo beer is mo better poster

2023 Engineering Design Expo

Design, build, impact
The 2023 Engineering Design Expo is a culmination of Allen School of Engineering and Computing students working in collaboration with many individuals, companies and organizations. We are extremely appreciative of our industry sponsors and those who have contributed so much of their time, talent, materials and support. Despite the recent challenges in our world, we are continuing to grow in our ability to offer innovative research and industry-based projects for our students.
Jim and Joan Bock Department of Biomedical Engineering
Adaptive skiing is a sport that allows people with disabilities to participate in the same type of ski events as people skiing in a traditional manner. Partnering with Adaptive Adventures and BAE Systems, this BME senior design team developed a thermosensing sock that sends skin temperature readings and warnings to adaptive skiers’ phones. This will allow adaptive skiers to enjoy skiing while reducing risk of frostbite.
Members: Paige Schiebel, Myles Cline and Holden Martin
The Catheter Lab Trainer 2.0 project aims to produce a medical simulation device that accurately models the human circulatory system in order to teach inexperienced physicians how to perform catheterization procedures, such as Watchman device implementation.
Members: Kanny Huang, Jack Konicek, Lilly Speier and Oliver Zhao
The Adapted Trike team was tasked with creating a solution for the customer, a woman with Multiple Sclerosis, to ride a tricycle. The trike will accommodate for the customer's symptoms, weakened right extremities and fatigue, with use of an electric assist, modified pedal and adapted seat.
Members: Chloe M. Goff, Victoria A. Green, Samantha M. Underhill and Cole R. Sullivan
Sleep-related infant death remains problematic. The design team designed a Safe Sleep Testing Infant to collect relevant data on unsafe infant sleep scenarios using electronic sensors. The device can certify infant sleep products as safe and educate parents on safe infant sleep practices.
Members: Cameron Hall, Aaron Streit, Remington Trick and Julia Zyck

Joint mobilizations are therapeutic techniques that are difficult to learn from a
textbook. The Trine University Department of Physical Therapy tasked our biomedical
engineering senior design team to design a robust trainer capable of identifying all
five grades of mobilization using circuitry, programming and mechanical design.
Members: Grant Dickinson, Bethany Ulring, Owen Engel and Samantha Weaver
In partnership with Quality of Life Plus and the Veterans Adaptive Sports & Training Program, the BME senior design team at Trine University, Archers' Choice, has designed and manufactured a modified archery stand that will allow disabled veterans to participate in the sport of archery.
Members: Matthew R. Sylvester, Zharia S. Dodson, Hoang L. Nguyen and Austin C. Stauffer
Our team was presented with a challenge from Parkview Mirro Center for Research and Innovation to design a neonatal thoracostomy task trainer. The trainer will allow physicians to perform needle decompression or chest tube insertion to alleviate pressure build-up within the pleural cavity.
Members: Alayna Willitzer, Garrett Howell, Shea Kreinbrink and Brett Tierney
McKetta Department of Chemical and Bioprocess Engineering
The purpose of this design is to capture and purify CO2 from an exhaust stream from industrial mixers. This exhaust stream includes volatiles and N2 that must be removed to ensure recovered CO2 is beverage-grade quality. This process will save the company money and reduce its carbon footprint.
Members: Elizabeth Curtis, Ellen Goff and Meg Yerrington
Carmeuse's environmental initiative reduces its CO2 footprint by converting flue gas from a limestone kiln into methanol. CO2 is purified, separated from other waste gases and reacted with hydrogen to produce methanol, reducing the carbon footprint and creating a new energy source.
Members: Adam Anderson, David Deniston and Mutlaq al Mutlaq
The design initiative had two objectives: to design a system for transporting brewing grains and to establish safe standard operating procedures in a brewery. The procedures will be accessible through links to instructional documents detailing the safety standards for each piece of equipment.
Members: Collin J. Elston, Jeremiah Evans, Timothy Doody and Andrew Michalowski
Our task was to examine the cost-effectiveness of installing variable frequency drives (VFDs) on pumps at Poet Bioprocessing. By utilizing VFDs to regulate fluid flow utility, costs could be reduced. The data collected will be used to determine under what conditions the VFDs should be purchased.
Members: Gabriel Smith and Chase Braxmaier
Reiners Department of Civil and Environmental Engineering
Students designed a roundabout to be located at the intersection of N 200 W and W 100 N in Angola, Indiana. Roundabouts increase traffic flow and reduce serious accidents. Students surveyed the site, performed turn counts and designed the roundabout geometry, pavement and site drainage.
Members: Justin Balcer, Colin Nicoski and Noah Ballard
The City of Angola needs to expand its wastewater treatment capacity, as the city's population and Trine University enrollment grow. Students evaluated adding new clarifiers, aeration tanks and primary tanks to treat wastewater to allow for future growth and new Indiana Department of Environmental Management phosphorus limits.
Members: Adam Stefanelli, Alex Mullet, Ben Toole and Bill Kennelly
The idea behind this design is that there is no safe and convenient way to get from the south side of town to the businesses that are located along N. Wayne Street on the north side of the railroad. There is also a problem with degrading and insufficient stormwater management in the project area so a new stormwater management system will be put in to reduce the amount of flooding in the area.
Members: Ryan Wisman, Braydon Cape and Mariah Rodriguez
Students designed a concrete canoe for the annual ASCE competition. Students researched, designed, produced and tested several concrete mixes to find the right combination of strength, workability and durability. They built a full-scale prototype and participated in a regional competition.
Members: Benjamin Stoffel and Grant Winterkorn
As Trine University's enrollment continues to grow, a dorm expansion plan is needed to keep up with enrollment and allow the traditional dorms to be demolished. Five new buildings will be constructed which will provide a total of 600 new beds.
Members: Amer Alsulami, Jacob Barkey, Josh Elmore and Avery Fulford
The senior design project was to design a general dormitory building for Trine University. The project was to add more on-campus housing for students behind Moss Street Apartments. The houses on the site will be torn down to accommodate this project. Five dorms will be orientated on the site with parking and a small green space.
Members: Hallie Fenimore, Makenna Sheets and Lia Vawter
Students designed a roundabout located at the intersection of Old U.S. 27 and Baker Road in Fremont, Indiana. Roundabouts increase traffic flow and reduce serious accidents. Students surveyed the site, performed traffic counts and designed the roundabout geometry and site drainage.
Members: Ryan Kafer, Dustin Huffer, Grant Patrick and Riley Garling
Our team designed a new Student Design Center to replace the existing one at Trine University. The project included soil testing, structural design of a steelframed building, foundation design, sustainability considerations and site design. The team designed a new SDC using RISA 3D computer software.
Members: Aspen Fisher, John Nash and Austin Zank
Department of Computer Science and Information Technology
An Asset Security Scanner that scans, stores and visualizes security findings to help IT staff manage their attack surface, the points where unauthorized users could enter or extract data, was developed. This application leverages Censys, Grafana and MySQL, and has a back end written using Python. Attack surfaces are visualized based on user-provided flags and hosts.
Members: Eric Gaby, Tanner Johnston, Jalan Albea, Drew Shilling, Tim Jones and JT Thomas
It is our mission to provide an accessible and comprehensive community calendar for the DeKalb County community. The various community organizations of DeKalb County will be able to submit events to the application. After approval, the public will be able to search events going on in their community.
Members: Aaron Bello, Cameron Luzadder, Peyton Sparks, LaMarr Smith, Val Roudebush and Veronica Ocampo
The purpose of this project is to increase cybersecurity measures; to help prevent and handle any attacks that may arise against Fernwood Botanical Garden. The main goal is to identify current data security risks, implement detection/protection measures and propose policy changes.
Members: Teddy Y., James C., Peyton D., Emily K., Charles A. and Kyle G.
We are creating a virtual tour for the entire Angola campus. This will allow potential students to view campus from the comfort of their own home. We want to show students the ins and outs of each building on campus, so they can make an informed decision on coming to Trine University.
Members: Drake Beber, Sam Bhandal, Nathaniel Brooks, Jonathon McCoy, Lexi Sunday and Taylor Taft
Department of Design Engineering Technology
An existing 3D-printed child's prosthetic was modified for improved fit, comfort and function for completion of common tasks such as playing with toys and riding a bicycle. The new design includes an improved grip mechanism and an additional bicycle attachment.
Members: Colton Kuchta, Ryan Norfleet and Samuel Ryan
This design is of a ready-to-assemble cardboard casket to minimize shipping size and cost of existing designs. The design includes use of combustible materials and elimination of metal hardware, resulting in an affordable, environmentally-friendly, easy-to-use product for funeral homes and individuals.
Members: Kodi Engle, Noah Sparks, Mason Angel and Alec Schultz
Our project goal was to increase production efficiency for an existing cardboard casket production facility. The final solution includes an adjustable-height production table with improved fixturing to allow completion of multiple processes and eliminate unnecessary material handling.
Members: Riely Novak, James Hancock, Joseph Emenhiser and Riley McGuire
The dock tool simplifies removal and installation of dock sections while incorporating portability, stowability, ease of assembly and adaptability for different types of docks. The dock is lifted vertically, flipped and rolled to shore while reducing overall size and weight from previous designs.
Members: Gena Mack, Sydnee Liedel, Caleb Price and Rilye Cox
Trine University worked with Turnstone and the U.S. National Women's Goalball team to develop a throwing device for use during practice. Goalball is a Paralympic team sport for blind and visually impaired people. The throwing device is crucial to prevent repetitive motion injuries during practice.
Members: Angelo Lerma, Xavier Ordaz and Philip Ollie
Hendrickson has a process to cut metal tubing to size that produces long shavings. The team has designed a shredding device that collects the shavings and reduces the size for safer handling. This machine is also mobile and can be repositioned for ease of swapping bins and material disposal.
Members: Konrad Dorsey, Isaac Krueger, Aidan Lapp and Conor O'Neill
The mower deck trimmer is a continuation project that improves the previous design completed by students in 2021. This new design uses a self-feeding head and a better electric motor with controls located near the rider. A new guard allows the user to maintain the trimmer unit with less effort.
Members: Brady Henderson, Daniel Milostan and Benjamin Mullet
Our team designed a two-person, human-powered vehicle to traverse obstacles and complete tasks similar to those encountered on the moon or other planets. The vehicle must meet size, weight and maneuverability requirements. This is an annual competition hosted by NASA at the Space and Rocket Center in Alabama.
Members: Jacob Clark, Reagan Guthrie, Austin Hensley, Emma Oslakovich, Michael Simmons and Ernesto Vieyra
This project entailed redesigning a grooming machine for the hiking trails at Pokagon State Park. This will allow park personnel to maintain the trail surfaces and recondition them throughout the year. The machine will be towed behind a John Deere 419 tractor and operated by one person.
Members: Andrew Dixon, Travis Dowling, Holt McNeer and William Thonn
Department of Electrical and Computer Engineering
Euphony is a communications app taking inspiration from current applications such as Discord and Zoom. It is designed for classrooms and organizations, with added administrative features such as a calendar system and user management to provide administrators with the tools to manage their groups.
Members: Darius Surgenavic, Jacob Myers and Jack Lehner
Our team of two electrical engineers and one computer engineer has designed an assembled a maze-solving robot to compete in the NRC Micromouse event. Our robot uses sensors to detect its surroundings and measure its traveled distance. After mapping the maze, it attempts to race back to the start.
Members: Kienan Miller, Loay Arrashoud and Marcus Miller
The Fox Transmitter can switch power modes to reach more than a 10-mile radius over a two-meter frequency using programmable tones. An OLED will show the frequency and the power mode. Another display will show the battery life of the device. This versatile design will appeal to everyone.
Members: Dakotah Alumbaugh, Ryan Brown, Noah Markus and Grace Shollenberger
The objective of this project is to create an autonomous lawnmower capable of mowing a small flat yard by utilizing LiDAR and a camera for object detection and tracking the robot's location and orientation in the yard, utilizing a self-generated map to navigate the terrain.
Members: Erich Vernon, Joseph Jaffray and Nathaniel Warfield
Wade Department of Mechanical and Aerospace Engineering
This project details the design, manufacture and testing of Mjölnir, a remote-controlled airplane designed for the 2022-2023 AIAA Design/Build/Fly competition. The competition consists of a ground mission and three flight missions, each with specific target tasks. This year's theme is Electronic Warfare.
Members: Dallas Kaylor, Robert Kortas, Matt Weis, Julia Frame, Lane Francis, Chasten Wilde and Zach Griffith
This project consists of designing, building and testing a device that measures the inner diameter of a five-gallon bucket. Reducing errors helps Berry Global save time and money by decreasing resources spent on reworking bad parts.
Members: Jenna Winsett, Madelyn Summers, Taylor Swymeler and Wade Kingrey
Trine has competed in the BUV BUVpetition over the past few years and looks to uphold its title this year. The team will compete in an endurance competition that spans seven hours where the team must complete as many laps as possible around the 2.2-mile course.
Members: Cameron Ickes, Jacob Schuler, Nash Kuney, Josh Belanger, Dylan Early and Garrett Adams
Students were challenged to create an authentic African Spear Point by exploiting the steel casting manufacturing process. Through this senior design project, students learned how century-old casting techniques are being adapted to modern technologies.
Members: Matthew Burnell, Ashley Jeffirs, Juliana Kitzmann, Kali Pullin and Adam Scheiner
This project consists of the design and build of an automated machine that applies a bead of silicone sealant along the edges of select components on specialty circuit card assemblies. Design and fabrication issues include aspects such as safety to people and components, automation and control.
Members: Dalton Bell, Zachary Hoehn, Eli Pfotenhauer, Alex Taylor and Josh Williams
This project consists of the design, build and competition of a combat robot in the "Beetleweight" division of the National Robotics Challenge. The robot utilizes a shuffle mechanism for movement, and a spinning metal bar for the weapon. The bot will compete in head-to-head competition.
Members: Jalen Gardner, Alex Good, Cameron Johnson, Nathaniel Scranton and Trevor Rice
This project is a continuation of prior work and looks to adapt and complete the design of a machine used to split large rolls of foam into two sheets. The machine must split and re-roll the split foam autonomously. The project includes aspects of controllers (PLC)PLCensing, fabrication and more.
Members: Austin Armstrong, Kyle Naif, YuliYulia, Hay Louison and Andrew Fisher
Trine's Design Build Launch senior design team had the challenge of building a high-power rocket that would be able to reach a pre-preermined apogee and deploy a payload that, once landed, would autonomously receive radio frequency signals to perform a series of tasks with an onboard camera.
Members: Ismar Chew, Myles Taylor, Makena Thompson, Ellie Trine and Michael Worosz III
The objective of this project was to determine changes in tennis ball rotations per minute based on the application of a tacky substance to tennis racket strings. Data was produced for the coefficient of friction for strings and rackets. High-speed camera imaging was used to determine the rotational speed data of a tennis ball.
Members: Afolabi Eniitan, Caleb Kruse, Carmen Sweigard and Cameron VanderMolen